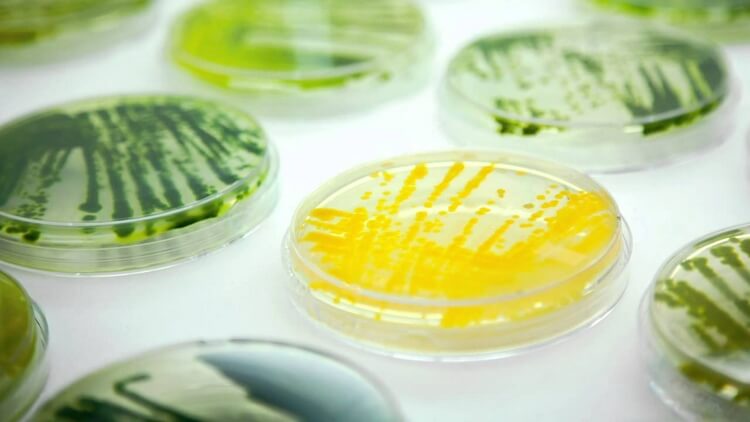

-

-
秋冬干燥季来临,皮肤干燥、小细纹这些问题最容易出现了,作为La Mer修复精华最好的替代品,奥杰尼的“时光小白瓶”效果的确是让人惊艳的。今年秋冬就让小白瓶温柔抚平你的肌肤吧!
-

-
生物科技加持 · 抗老事半功倍
“时光小白瓶”中的秘密成分就是多糖酸Alguronic Acid,它具有强大的抗衰老、紧致皮肤的天赋。还有另外一种提取自微藻类的物质Microalgae Oil (微藻类油),它对皮肤的保湿、滋养能力极强。在24小时内,涂抹了微藻类油的皮肤比没有涂抹的皮肤的含水力强5倍。
-
-
Algenist奥杰尼所有产品都基于多糖酸和微藻类油。 有效的在滋润保湿皮肤的同时很好的帮助肌肤抗衰老、紧致肌肤。
-

-
时光小白瓶的时光秘密
其中除了李嫣视频中被曝光的“爆水霜”,还有一个非常受欢迎的明星产品:“时光小白瓶”。而它其中所蕴含的秘密武器正是多糖酸。
-

-

-

-
“多糖酸来自于微藻萃取,微藻属于生命力极强的藻类,具有强大的细胞再生能力,它可以快速淡化深层皱纹,紧致肌肤并增加光泽度。同时搭配维他命,胜肽和抗氧化物复合物等经典的抗老成分,经医学证明可以在10日内淡化深层皱纹‼️”
-
来看看Algenist(奥杰尼)官网上这个五星好评的商品评价吧!

- 86% 的用户在使用10日内有提升肌肤密度的效果- 93% 的用户在使用10日内有明显肤色提亮的效果- 79% 的用户在使用4周内有深纹明显减少淡化的效果- 81% 的用户在使用4周内有显著的皮肤紧致和提升的效果
-

-

-

修复精华 (时光小白瓶)
奥杰尼 Algenist
$98 (约¥662)点击购买• 最大限度地减少皱纹的出现 • 肌肤密度,弹性和坚定性出现恢复 • 让肌肤光采焕发 这款精华的质地是很轻薄的白色乳状,质地丝滑且细腻,很好推开也很好吸收,你会觉得滋润的同时又很清爽,特有的无油配方,让油皮也可以放心的使用,或者干皮更适合在夏季使用。精华非常温和,连脆弱的眼周都能安全使用,这样同时照顾到眼部肌肤,随时对抗眼周的细纹、干纹。
